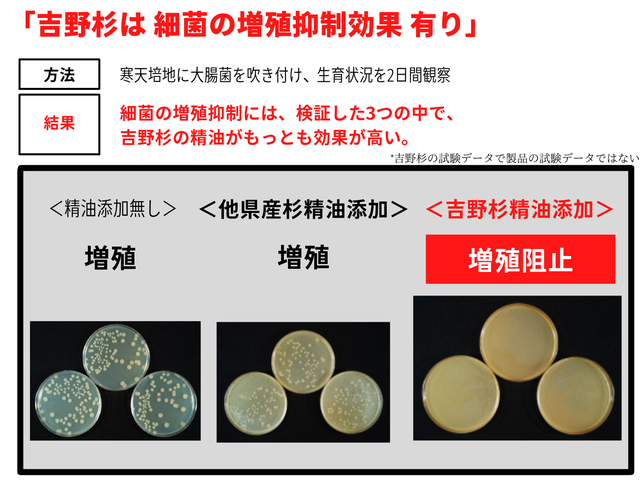

プロジェクト実行者
ストーリー
- 高い耐久性!驚きの軽さ!持ち運び可能な取っ手付きで、アウトドアにも持ち出せるスマートさ!
- 防カビ・防菌に優れた吉野杉。木の吸湿性により、適度な湿度に調整され、食品の常温保存に優れる!
- 奈良県の家具職人により、手作りで造られる逸品。ひとつひとつ木目が異なる、世界に一つの贈り物。




衝撃の軽さ!持ち運び可能な、一斤用パンケース
ごはんのおひつのように、食パン専用のケースを吉野杉でつくりました。
いつもの食パンがちょっとリッチな風合いに。ほのかに香る自然の杉の香りが美味しさを引き立たせてくれます。
吉野杉はカビの生育抑制、細菌の増殖抑制、吸湿性に優れ、木の吸湿性により、箱の中が適度な湿度に調整されるので、食パンの保存には適しています。(吉野杉の素材特性 )


奈良県奥大和の木工家具職人がひとつひとつ手作りで製作
森林面積が9割を占める奈良県南部東部「奥大和」エリアには、その地に根付いてものづくりを営んでいる人たちが、たくさんいます。豊かな自然環境の中でこそ磨かれる、技術や精神によって生み出された、逸品に是非出会ってください。


年を経るごとに、味わい深く、その木でしか表現できない美しさや味わいが増していきます。
奈良の吉野杉は年輪幅が細かく均一で、密度が高いことから、一般的なスギに比べて、強く・たわみにくいという性質があります。


美しい木目は、自然が歳月をかけて生み出すデザイン。心を落ち着かせ、穏やかにするといわれています。
奈良奥大和では、木を密集して植えるため吉野杉の枝は自然に枯れ落ちます。枝が落ちることで節が少なく、また年輪が細かく均一な木に育ちます。さらに、奈良の木はまっすぐに成長するため、木目も直線で美しいという特長もあります。


色合いを楽しむことができるのも、美しい色が特長である奈良の木だからこそです。
吉野杉の心材は、ほかの地域のスギには見られにくい赤み混じりの上品な色合いです。その独特な色合いは、古くから高級和室の内装などにも使われてきました。白くて美しい辺材は清潔感が魅力的で、高級割り箸などに加工されています。




「試験を実施した自社も驚きの結果に!!!」
自社試験として、数日間か食パン(賞味期限前)を入れてみたところ、品質が長持ちしました。(※念のため、賞味期限前にお早めにお召し上がりください)
(*使用環境によって程度は異なります)

細部までこだわり抜いた、職人の逸品。
・箱の組み立てに金属を使わず、職人の技「かんざし加工」を実施
・さらに見栄えに拘り、製品の外側にはウレタンコーティングを実施

・軽い吉野杉!ご自宅からそのままアウトドアに持ち出せる取っ手付き



・スライド式の蓋は、横開きにも縦開きにもできます。


・コンパクトなので、収納にも困りません。

・食パンだけでなく、焼き菓子などを入れても、お使いいただけます。


<サイズ>
内寸 d184×w157×h156
外寸 d200×w173×h180



「Wait a minutes」
・慌ただしい日常生活に一息ついて、Out DoorでChill Outしよう。
・一度立ち止まって考えよう、日本の森のこと。
「Made in Nara」
・奈良県奥大和の家具職人と奈良の木で造り上げる五感に響くProduct。


木目が美しく耐久性の高い吉野杉・檜を代表とする、奈良の木は、使い続けることで味が出る、五感に響くProduct

Out Door専用でもなく、In Door専用でもない。
非日常(Out Door)と日常(In Door)の両シーンで活躍する、スマートな Out Door & In Door Style

洗練された家具職人が手掛けるけど決して頑固では無い。
新しいProduct System(仕組みやアイデア)を取り入れたTraditional & Modern Style

(少し文章が長く申し訳ございませんが、お読みいただけますと幸いです。)

「未来へ紡ぐ・五感に響くプロダクトを」
MiNは、吉野杉や檜などの奈良の木で、奈良奥大和の家具職人によりつくられるOut Door & In Door のキャンプブランドです。
木から感じる癒やし、ぬくもり、美しさは、生命を宿した素材だからこそ、私たちの暮らしにしっくりと馴染むのではないでしょうか。日本では古くからそのような木の価値が大切にされてきました。
便利さを追求した現代社会だからこそ、一度立ち止まって考えてみてください。
キャンプ用品の主流は、アルミやチタン、輸入木材。
国土の3分の2が森林を占める自然豊かな日本において今、国産木材の需要は減り、森林は荒廃しています。
木を育てても売れないため、手入れが滞り、さらに手入れが必要な森林が増え続けるという悪循環に陥っているのです。
木を伐採することは悪いことと考えている人が多いようですが、実はそれは大きな誤解です。
日本の人工林はもっと伐採して使うことが求められています。
植えられた木が伐採されずに放置されていると、幹も根も十分に育たず下草も生えにくいため、
森林の土壌を守る機能が損なわれてしまい、大雨が降った際には土砂崩れなどの災害が起きる危険が高まります。
森林の機能を十分に発揮させるためには、適度に伐採を行い、利用し、新たに苗木を植えるサイクルが必要なのです。
森が元気になるということは、昆虫から哺乳類までのすべての野生動物の命や暮らしを守っていくことにもつながります。
そして、私たちの命や暮らしが健全に守られているということにもつながっているのです。
木々が二酸化炭素を吸収することによる地球温暖化の防止、豊かな水源を蓄える働きや、洪水・土砂災害の防止など、
森が私たちにもたらす恩恵はさまざまです。
自然をRespectする皆様に、未来を紡ぐ・五感に響く「MiN」のProductをお届けすることで、日本の森林を守り、Sustainableな社会を実現します。


「森木工所」
ここまでお読みいただきまして、誠にありがとうございます。
創業は、大正初め頃(林業・製材業)で歴史のある木工所です。
奈良県吉野郡黒滝村赤滝にある吉野杉を素材とした日本料理等の器やオーダーメイドのテーブル等の家具を製造しております。
吉野杉は、国産材のブランドのひとつであり、秋田杉・木曽桧とともに日本三大美林と讃えられる美林で生まれます。造林史上最古と言われる植林の地、奈良県吉野。
吉野郡川上村には、現在も樹齢380年ほどの杉の人工林が残っています。300年を超える樹齢。どんな技術をもっても、どんな資源をもっても決して真似できません。
吉野材の最大の特長は、芯が円心にあり曲がりが少なく、年輪巾が適度に細かく均一であること。そして色つやが良く光沢にとんでいることです。年輪巾が細かく均一であるということは、そのまま強度が高いということにも繋がります。
そのため江戸時代以降から樽や桶の素材としても重宝されてきました。森木工所では、樹齢平均60~80年の樹を主に使用しております。
<注意事項>
本物の木ならではの味わいとしてお楽しみください。
・デザイン・サイズについて
天然木を使った製品のため、木目や色味が写真とは若干異なる場合があります。
また、一品一品手作業を含む作業を行うため、記載サイズより若干異なる場合があります。
・“節(ふし)”について
節が少ないと言われる吉野杉ですが、中には稀に“節”が入ります。節はもともと枝が付いていた跡で、傷ではありません。
ポロリと抜け落ちる可能性のある枯れた枝の節以外の、元気な節はそのまま自然な形で、製品の一部として使用する場合があります。
・小さな“欠けや割れ”について
大きな丸太がそれぞれの製品となるまでに、様々な加工の工程があります。
その中でどうしても発生する、天然木ならではの小さな欠けや割れには補修処理を行い、出来る限り平らにしています(曲線部分や細かい箇所などは、補修処理をできない場合もあります)。
・耐荷重について
食パンや焼き菓子等の軽いモノを入れてご使用ください。
・ご使用方法
食品を入れるときはペーパーナプキンやワックスシートなど敷紙を敷いてご使用ください。害はありませんが食品の油分が付着し、シミの原因となります。
持ち運びされる際は、振り回さないようご注意ください。スライド式の蓋が開くことがあります。
・お手入れ方法
水や汚れは、水やお湯を固く絞ったふきん等で拭きとって下さい。内側が水で濡れたり、湿っている場合は蓋を開け乾燥させてからご使用ください。
・保管方法
直射日光、高温・多湿を避け、ご使用ください。
・食パンケースのお取り扱いをご希望の企業様は、プロジェクトページ上部の ✉実行者へ問合せ よりお願いいたします。
・スケジュール
2022年1月末:プロジェクト終了
2022年3月初:リターンのご発送
リスク&チャレンジ
キャンセルポリシー ※本文中に記載させていただいたスケジュールは、あくまでプロジェクト公開時点の予定です。応援購入の性質上、配送遅延のおそれがございます。 ※原則として、配送遅延に伴う応援購入のキャンセルはできませんが、リターン配送予定月から3ヵ月を超えた場合には、希望者に限りキャンセルにて対応させていただきます。 【スケジュールについて】 ・製造スケジュールについては、現在プロジェクト成功を想定した数で調整しておりますが、ご支援の数が想定を上回った場合、製造工程の都合や配送作業に伴うやむを得ない事情によりお届けが遅れる場合がございます。 【キャンセルについて】 ・キャンセルについて 、ご支援後のご支援様都合によるキャンセルや返金は受付いたしませんのでご了解ください。 後に、『吉野杉のパンケース』を手に取ったみなさまに喜んでもらえるよう、心を込めて対応していきますので、応援よろしくお願い致します。
サポーターからの応援コメント
文章のトップに戻る
応援購入する
このプロジェクトはAll in型です。目標金額の達成に関わらず、プロジェクト終了日の2022年01月23日までに支払いを完了した時点で購入が成立します。
(早割5%オフ)吉野杉のパンケース1個(消費税・送料込み)

12,350円(税込)
・完成したパンケース1個
(一般販売予定価格\13,000)
取っ手を「無色」か「バターミルクペイントの緑色」を選択可能です。
*バターミルクペイントとは、ミルクに含まれるガゼイン(リンを含むタンパク質の一種)と天然の顔料で作られた人や環境にやさしい自然塗料で、仕上がりに味がありアンティーク塗装やビンテージ加工におすすめの塗料です。
*製品準備が早く完了した場合は、3月以前に発送させていただきます。
吉野杉のパンケース1個(消費税・送料込み)

13,000円(税込)
・完成したパンケース1個
(一般販売予定価格\13,000)
取っ手を「無色」か「バターミルクペイントの緑色」を選択可能です。
*バターミルクペイントとは、ミルクに含まれるガゼイン(リンを含むタンパク質の一種)と天然の顔料で作られた人や環境にやさしい自然塗料で、仕上がりに味がありアンティーク塗装やビンテージ加工におすすめの塗料です。
*製品準備が早く完了した場合は、3月以前に発送させていただきます。
(超早割10%オフ)吉野杉のパンケース2個(消費税・送料込み)

22,230円(税込)
・完成したパンケース2個
(一般販売予定価格\26,000)
取っ手を「無色」か「バターミルクペイントの緑色」を選択可能です。
*バターミルクペイントとは、ミルクに含まれるガゼイン(リンを含むタンパク質の一種)と天然の顔料で作られた人や環境にやさしい自然塗料で、仕上がりに味がありアンティーク塗装やビンテージ加工におすすめの塗料です。
*製品準備が早く完了した場合は、3月以前に発送させていただきます。
(早割5%オフ)吉野杉のパンケース2個(消費税・送料込み)

24,700円(税込)
・完成したパンケース2個
(一般販売予定価格\26,000)
取っ手を「無色」か「バターミルクペイントの緑色」を選択可能です。
*バターミルクペイントとは、ミルクに含まれるガゼイン(リンを含むタンパク質の一種)と天然の顔料で作られた人や環境にやさしい自然塗料で、仕上がりに味がありアンティーク塗装やビンテージ加工におすすめの塗料です。
*製品準備が早く完了した場合は、3月以前に発送させていただきます。
吉野杉のパンケース2個(消費税・送料込み)

26,000円(税込)
・完成したパンケース2個
(一般販売予定価格\26,000)
取っ手を「無色」か「バターミルクペイントの緑色」を選択可能です。
*バターミルクペイントとは、ミルクに含まれるガゼイン(リンを含むタンパク質の一種)と天然の顔料で作られた人や環境にやさしい自然塗料で、仕上がりに味がありアンティーク塗装やビンテージ加工におすすめの塗料です。
*製品準備が早く完了した場合は、3月以前に発送させていただきます。
(バイヤー様向け)吉野杉のパンケース5個(消費税・送料込み)

48,750円(税込)
・完成したパンケース5個
(一般販売予定価格\13,000)
取っ手を「無色」か「バターミルクペイントの緑色」を選択可能です。
・MiNブランドのリーフレットや説明書も送付させていただきます
*バターミルクペイントとは、ミルクに含まれるガゼイン(リンを含むタンパク質の一種)と天然の顔料で作られた人や環境にやさしい自然塗料で、仕上がりに味がありアンティーク塗装やビンテージ加工におすすめの塗料です。
*2月初旬に発送させていただきます。
・本リターンはバイヤー会員に向けたものであるため、万が一バイヤー会員でないサポーター様が応援購入された場合には実行者判断をもって注文をキャンセルとさせていただきます。ご理解・ご了承のほどよろしくお願いいたします。
(バイヤー様向け)吉野杉のパンケース10個(消費税・送料込み)

97,500円(税込)
・完成したパンケース10個
(一般販売予定価格\13,000)
取っ手を「無色」か「バターミルクペイントの緑色」を選択可能です。
*バターミルクペイントとは、ミルクに含まれるガゼイン(リンを含むタンパク質の一種)と天然の顔料で作られた人や環境にやさしい自然塗料で、仕上がりに味がありアンティーク塗装やビンテージ加工におすすめの塗料です。
*2月初旬に発送させていただきます。
・本リターンはバイヤー会員に向けたものであるため、万が一バイヤー会員でないサポーター様が応援購入された場合には実行者判断をもって注文をキャンセルとさせていただきます。ご理解・ご了承のほどよろしくお願いいたします。
(超!超早割!15%オフ)吉野杉のパンケース1個(消費税・送料込み)

11,050円(税込)
・完成したパンケース1個
(一般販売予定価格\13,000)
取っ手を「無色」か「バターミルクペイントの緑色」を選択可能です。
*バターミルクペイントとは、ミルクに含まれるガゼイン(リンを含むタンパク質の一種)と天然の顔料で作られた人や環境にやさしい自然塗料で、仕上がりに味がありアンティーク塗装やビンテージ加工におすすめの塗料です。
*製品準備が早く完了した場合は、3月以前に発送させていただきます。
(超早割10%オフ)吉野杉のパンケース1個(消費税・送料込み)

11,700円(税込)
・完成したパンケース1個
(一般販売予定価格\13,000)
取っ手を「無色」か「バターミルクペイントの緑色」を選択可能です。
*バターミルクペイントとは、ミルクに含まれるガゼイン(リンを含むタンパク質の一種)と天然の顔料で作られた人や環境にやさしい自然塗料で、仕上がりに味がありアンティーク塗装やビンテージ加工におすすめの塗料です。
*製品準備が早く完了した場合は、3月以前に発送させていただきます。
「Makuake(マクアケ)」は、実行者の想いを応援購入によって実現するアタラシイものやサービスのプラットフォームです。このページは、 プロダクトカテゴリの 「どこにでも持ち運べて、保存時にカビの生育抑制もできる。吉野杉の「食パンケース」」プロジェクト詳細ページです。








